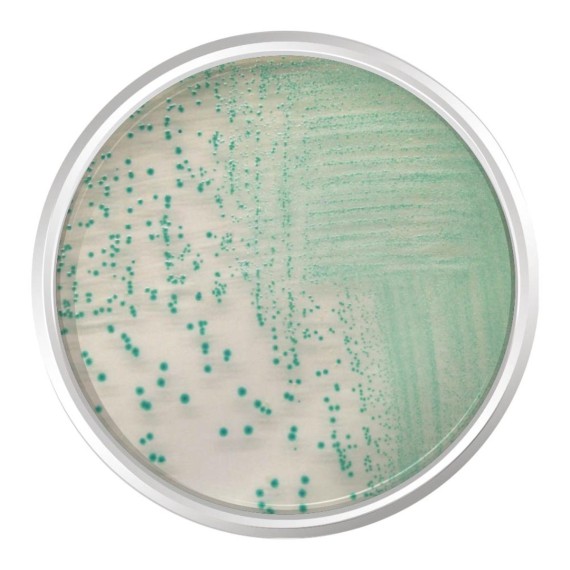

O Agar Cromogênico TBX é um meio para detecção e enumeração de Escherichia coli em alimentos.
Controle de Qualidade:
Microrganismos Crescimento Cor da Colônia
44°C 37°C
Escherichia coli (ATCC 25922) Bom Bom Azul esverdeado
Salmonella typhimurium ATCC 14028 Inibido Inibido Sem cor
Enterococcus faecalis (ATCC 19433) Inibido Inibido Sem cor
Klebsiella pneumoniae (ATCC 13883) Inibido Inibido Sem cor
-Registro ANVISA: Não aplicável.
-Apresentação: Frasco com 500 gramas.
-MODELO: K25-1151
-MARCA: KASVI
*MEIO VENDIDO SOB DEMANDA.